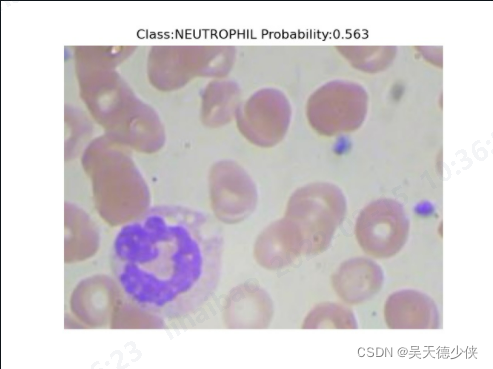

plt.ion()
plt.imshow(image)
plt.title(f'Class:{class_name} Probability:{probability:.3f}')
# 保存
plt.axis('off')
# saveDir+os.path.basename(filepath):d:/test.jpg
plt.savefig(saveDir+os.path.basename(filepath))
plt.show(block=False)
plt.pause(1) # 显示1s
plt.close()

3123
3123

 被折叠的 条评论
为什么被折叠?
被折叠的 条评论
为什么被折叠?








